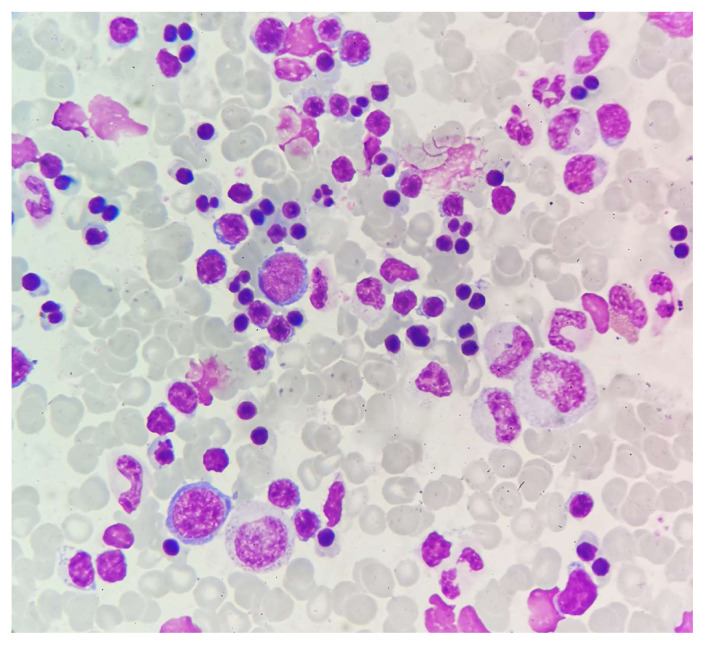

A Case of Congenital Dyserythropoietic Anemia Masked by Hemoglobin H Disease.
IF 1.5
4区 医学
Q3 HEMATOLOGY
Mediterranean Journal of Hematology and Infectious Diseases
Pub Date : 2024-07-01
eCollection Date: 2024-01-01
DOI:10.4084/MJHID.2024.059
引用次数: 0
一个被血红蛋白 H 病掩盖的先天性红细胞生成障碍性贫血病例
本文章由计算机程序翻译,如有差异,请以英文原文为准。
求助全文
约1分钟内获得全文
求助全文
来源期刊

Mediterranean Journal of Hematology and Infectious Diseases
Medicine-Hematology
CiteScore
4.20
自引率
6.20%
发文量
113
审稿时长
12 weeks
期刊介绍:
Reciprocal interdependence between infectious and hematologic diseases (malignant and non-malignant) is well known. This relationship is particularly evident in Mediterranean countries. Parasitosis as Malaria, Leishmaniosis, B Hookworms, Teniasis, very common in the southeast Mediterranean area, infect about a billion people and manifest prevalently with anemia so that they are usually diagnosed mostly by experienced hematologist on blood or bone marrow smear. On the other hand, infections are also a significant problem in patients affected by hematological malignancies. The blood is the primary vector of HIV infection, which otherwise manifest with symptoms related to a reduction in T lymphocytes. In turn, infections can favor the insurgency of hematological malignancies. The causative relationship between Epstein-Barr virus infection, Helicobacter pylori, hepatitis C virus, HIV and lymphoproliferative diseases is well known.
 求助内容:
求助内容: 应助结果提醒方式:
应助结果提醒方式:


